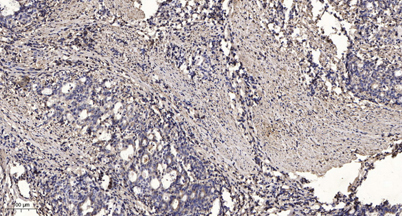

$148.00/50µL $248.00/100µL
| 50 µL | $148.00 |
| 100 µL | $248.00 |
| Product name: | T2R10 rabbit pAb |
| Reactivity: | Human;Rat;Mouse; |
| Alternative Names: | TAS2R10; Taste receptor type 2 member 10; T2R10; Taste receptor family B member 2; TRB2 |
| Source: | Rabbit |
| Dilutions: | WB 1:500-2000;IHC-p 1:50-300; ELISA 2000-20000 |
| Immunogen: | The antiserum was produced against synthesized peptide derived from human TAS2R10. AA range:122-171 |
| Storage: | -20°C/1 year |
| Clonality: | Polyclonal |
| Isotype: | IgG |
| Concentration: | 1 mg/ml |
| Observed Band: | 35kD |
| GeneID: | 50839 |
| Human Swiss-Prot No: | Q9NYW0 |
| Cellular localization: | Membrane; Multi-pass membrane protein. |
| Background: | This gene product belongs to the family of candidate taste receptors that are members of the G-protein-coupled receptor superfamily. These proteins are specifically expressed in the taste receptor cells of the tongue and palate epithelia. They are organized in the genome in clusters and are genetically linked to loci that influence bitter perception in mice and humans. In functional expression studies, they respond to bitter tastants. This gene maps to the taste receptor gene cluster on chromosome 12p13. [provided by RefSeq, Jul 2008], |